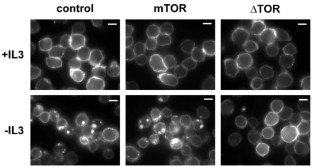

Abstract
In yeast, TOR couples cellular growth and metabolism to the availability of extracellular nutrients. In contrast, mammalian TOR kinase activity has been reported to be regulated by growth factor stimulation via the PI3K/Akt pathway. Consistent with this, growth factor deprivation results in dephosphorylation of the mTOR target proteins p70S6k and 4EBP1 in the face of abundant extracellular nutrients. To determine whether the activation of mTOR was sufficient to support cell survival in the absence of other growth factor-mediated signal transduction, we evaluated the ability of a growth factor-independent mTOR mutant, ΔTOR, to protect cells from growth factor deprivation. ΔTOR- but not wild-type mTOR-expressing cells were protected from many of the sequelae of growth factor deprivation including amino-acid transporter degradation, reduction of the glycolytic rate, cellular atrophy, decreased mitochondrial membrane potential, and Bax activation. Furthermore, ΔTOR expression increased growth factor-independent, nutrient-dependent cell survival and enhanced the ability of p53−/− MEFs to form colonies in soft agar. These results suggest that activating mutations of mTOR can contribute to apoptotic resistance and might contribute to cellular transformation.
This is a preview of subscription content, access via your institution
Access options
Subscribe to this journal
Receive 50 print issues and online access
$259.00 per year
only $5.18 per issue
Buy this article
- Purchase on SpringerLink
- Instant access to the full article PDF.
USD 39.95
Prices may be subject to local taxes which are calculated during checkout

Similar content being viewed by others
References
Abraham RT . (2002). Cell, 111, 9–12.
Aoki M, Blazek E and Vogt PK . (2001). Proc. Natl. Acad. Sci. USA, 98, 136–141.
Bouillet P, Metcalf D, Huang DC, Tarlinton DM, Kay TW, Kontgen F, Adams JM and Strasser A . (1999). Science, 286, 1735–1738.
Brunet A, Bonni A, Zigmond MJ, Lin MZ, Juo P, Hu LS, Anderson MJ, Arden KC, Blenis J and Greenberg ME . (1999). Cell, 96, 857–868.
Brunn GJ, Fadden P, Haystead TA and Lawrence Jr JC . (1997). J. Biol. Chem., 272, 32547–32550.
Cantley LC and Neel BG . (1999). Proc. Natl. Acad. Sci. USA, 96, 4240–4245.
Degenhardt K, Chen G, Lindsten T and White E . (2002). Cancer Cell, 2, 193–203.
Deves R and Boyd CA . (2000). J. Membr. Biol., 173, 165–177.
Di Cristofano A, Pesce B, Cordon-Cardo C and Pandolfi PP . (1998). Nat. Genet., 19, 348–355.
Dijkers PF, Birkenkamp KU, Lam EW, Thomas NS, Lammers JW, Koenderman L and Coffer PJ . (2002). J. Cell Biol., 156, 531–542.
Dijkers PF, Medema RH, Lammers JW, Koenderman L and Coffer PJ . (2000). Curr. Biol., 10, 1201–1204.
Edinger AL and Thompson CB . (2002). Mol. Biol. Cell, 13, 2276–2288.
Fingar DC, Salama S, Tsou C, Harlow E and Blenis J . (2002). Genes Dev., 16, 1472–1487.
Freedman VH and Shin SI . (1974). Cell, 3, 355–359.
Gao X, Zhang Y, Arrazola P, Hino O, Kobayashi T, Yeung RS, Ru B and Pan D . (2002). Nat. Cell Biol., 4, 699–704.
Garami A, Zwartkruis FJ, Nobukuni T, Joaquin M, Roccio M, Stocker H, Kozma SC, Hafen E, Bos JL and Thomas G . (2003). Mol. Cell, 11, 1457–1466.
Gottlob K, Majewski N, Kennedy S, Kandel E, Robey RB and Hay N . (2001). Genes Dev., 15, 1406–1418.
Gross A, Jockel J, Wei MC and Korsmeyer SJ . (1998). EMBO J., 17, 3878–3885.
Hardwick JS, Kuruvilla FG, Tong JK, Shamji AF and Schreiber SL . (1999). Proc. Natl. Acad. Sci. USA, 96, 14866–14870.
Hidalgo M and Rowinsky EK . (2000). Oncogene, 19, 6680–6686.
Hosoi H, Dilling MB, Shikata T, Liu LN, Shu L, Ashmun RA, Germain GS, Abraham RT and Houghton PJ . (1999). Cancer Res., 59, 886–894.
Inoki K, Li Y, Xu T and Guan KL . (2003a). Genes Dev., 17, 1829–1834.
Inoki K, Li Y, Zhu T, Wu J and Guan KL . (2002). Nat. Cell Biol., 4, 648–657.
Inoki K, Zhu T and Guan KL . (2003b). Cell, 115, 577–590.
Kim DH, Sarbassov DD, Ali SM, King JE, Latek RR, Erdjument-Bromage H, Tempst P and Sabatini DM . (2002). Cell, 110, 163–175.
Kinoshita T, Shirouzu M, Kamiya A, Hashimoto K, Yokoyama S and Miyajima A . (1997). Oncogene, 15, 619–627.
Kwabi-Addo B, Giri D, Schmidt K, Podsypanina K, Parsons R, Greenberg N and Ittmann M . (2001). Proc. Natl. Acad. Sci. USA, 98, 11563–11568.
Lazaris-Karatzas A, Montine KS and Sonenberg N . (1990). Nature, 345, 544–547.
Li L, Price JE, Fan D, Zhang RD, Bucana CD and Fidler IJ . (1989). J. Natl. Cancer Inst., 81, 1406–1412.
Manning BD and Cantley LC . (2003). Biochem. Soc. Trans., 31, 573–578.
McManus EJ and Alessi DR . (2002). Nat. Cell Biol., 4, E214–6.
Mills GB, Lu Y and Kohn EC . (2001). Proc. Natl. Acad. Sci. USA, 98, 10031–10033.
Nave BT, Ouwens M, Withers DJ, Alessi DR and Shepherd PR . (1999). Biochem. J., 344 (Part 2), 427–431.
Nechushtan A, Smith CL, Hsu YT and Youle RJ . (1999). EMBO J., 18, 2330–2341.
Neshat MS, Mellinghoff IK, Tran C, Stiles B, Thomas G, Petersen R, Frost P, Gibbons JJ, Wu H and Sawyers CL . (2001). Proc. Natl. Acad. Sci. USA, 98, 10314–10319.
Palacin M, Estevez R, Bertran J and Zorzano A . (1998). Physiol. Rev., 78, 969–1054.
Peng T, Golub TR and Sabatini DM . (2002). Mol. Cell. Biol., 22, 5575–5584.
Plas DR, Talapatra S, Edinger AL, Rathmell JC and Thompson CB . (2001). J. Biol. Chem., 276, 12041–12048.
Podsypanina K, Ellenson LH, Nemes A, Gu J, Tamura M, Yamada KM, Cordon-Cardo C, Catoretti G, Fisher PE and Parsons R . (1999). Proc. Natl. Acad. Sci. USA, 96, 1563–1568.
Podsypanina K, Lee RT, Politis C, Hennessy I, Crane A, Puc J, Neshat M, Wang H, Yang L, Gibbons J, Frost P, Dreisbach V, Blenis J, Gaciong Z, Fisher P, Sawyers C, Hedrick-Ellenson L and Parsons R . (2001). Proc. Natl. Acad. Sci. USA, 98, 10320–10325.
Potter CJ, Pedraza LG and Xu T . (2002). Nat. Cell Biol., 4, 658–665.
Raught B, Gingras AC and Sonenberg N . (2001). Proc. Natl. Acad. Sci. USA, 98, 7037–7044.
Saucedo LJ, Gao X, Chiarelli DA, Li L, Pan D and Edgar BA . (2003). Nat. Cell Biol., 5, 566–571.
Schmelzle T and Hall MN . (2000). Cell, 103, 253–262.
Scott PH, Brunn GJ, Kohn AD, Roth RA and Lawrence Jr JC . (1998). Proc. Natl. Acad. Sci. USA, 95, 7772–7777.
Sekulic A, Hudson CC, Homme JL, Yin P, Otterness DM, Karnitz LM and Abraham RT . (2000). Cancer Res., 60, 3504–3513.
Shinjyo T, Kuribara R, Inukai T, Hosoi H, Kinoshita T, Miyajima A, Houghton PJ, Look AT, Ozawa K and Inaba T . (2001). Mol. Cell. Biol., 21, 854–864.
Sonenberg N and Gingras A-C . (1998). Curr. Opin. Cell Biol., 10, 268–275.
Stocker H, Radimerski T, Schindelholz B, Wittwer F, Belawat P, Daram P, Breuer S, Thomas G and Hafen E . (2003). Nat. Cell Biol., 5, 559–565.
Suzuki A, de la Pompa JL, Stambolic V, Elia AJ, Sasaki T, del Barco Barrantes I, Ho A, Wakeham A, Itie A, Khoo W, Fukumoto M and Mak TW . (1998). Curr. Biol., 8, 1169–1178.
Tee AR, Manning BD, Roux PP, Cantley LC and Blenis J . (2003). Curr. Biol., 13, 1259–1268.
Vander Heiden MG, Chandel NS, Williamson EK, Schumacker PT and Thompson CB . (1997). Cell, 91, 627–637.
Vander Heiden MG, Plas DR, Rathmell JC, Fox CJ, Harris MH and Thompson CB . (2001). Mol. Cell. Biol., 21, 5899–5912.
Vogt PK . (2001). Trends Mol. Med., 7, 482–484.
Zhang Y, Gao X, Saucedo LJ, Ru B, Edgar BA and Pan D . (2003). Nat. Cell Biol., 5, 578–581.
Acknowledgements
We thank Dr Bob Abraham for providing the mTOR/ΔTOR constructs and for helpful advice throughout the project, all the members of the Thompson lab for providing both criticism and support, and Trevor Hoffman for scoring the soft agar assays and for helpful discussions. ALE was supported by a fellowship from the Helen Hay Whitney Foundation. CBT was supported in part by grants from the NCI.
Author information
Authors and Affiliations
Corresponding author
Rights and permissions
About this article
Cite this article
Edinger, A., Thompson, C. An activated mTOR mutant supports growth factor-independent, nutrient-dependent cell survival. Oncogene 23, 5654–5663 (2004). https://doi.org/10.1038/sj.onc.1207738
Received:
Revised:
Accepted:
Published:
Issue date:
DOI: https://doi.org/10.1038/sj.onc.1207738
Keywords
This article is cited by
-
Effects of glycosylation on the bioactivity of rapamycin
Applied Microbiology and Biotechnology (2020)
-
Identification and characterization of two novel oncogenic mTOR mutations
Oncogene (2019)
-
Nutrient scavenging in cancer
Nature Reviews Cancer (2018)
-
Considerations on mTOR regulation at serine 2448: implications for muscle metabolism studies
Cellular and Molecular Life Sciences (2017)
-
Resistance to Targeted Therapies in Renal Cancer: The Importance of Changing the Mechanism of Action
Targeted Oncology (2017)



